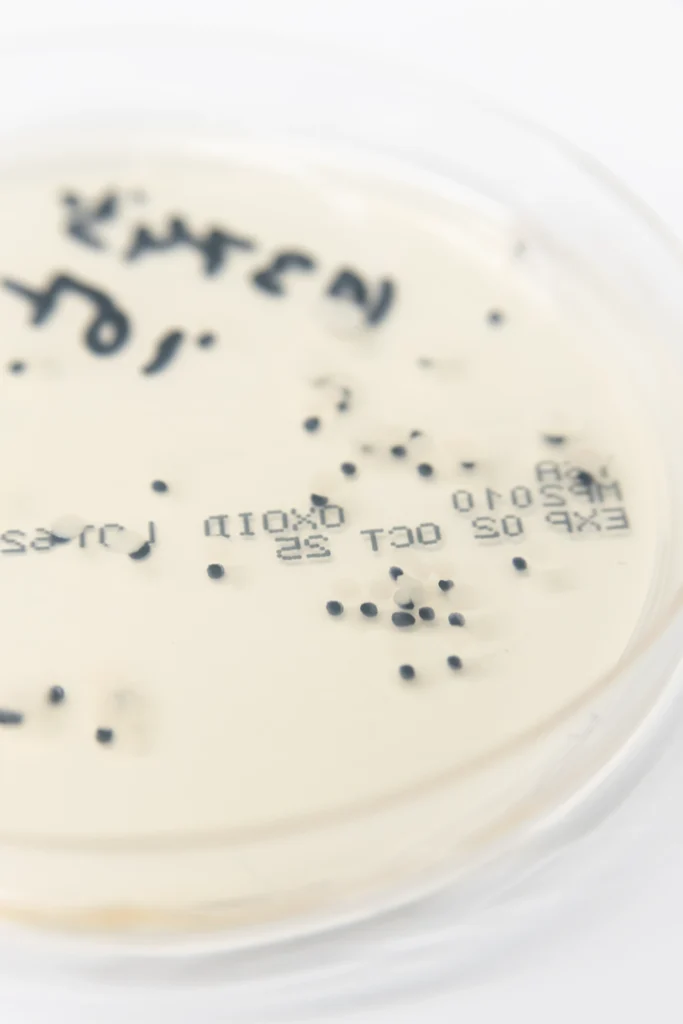

When wastewater gets salty:
a microbial breakthrough in extreme conditions

Treating wastewater is already a complex affair. But what happens when that water is not just dirty but salty, oily, and biologically hostile?
The stability of microbial consortia:
an underrated but critical challenge in formulation
Combining multiple microbial strains into a single formulation seems like a logical path toward performance. A well-designed consortium promises complementary modes of action, broader biological coverage, and greater resilience under field conditions. On paper, it’s a compelling strategy.